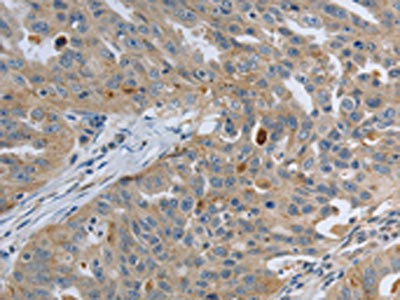

PAK4 Antibody
-
中文名稱:PAK4兔多克隆抗體
-
貨號:CSB-PA038167
-
規格:¥1100
-
圖片:
-
The image on the left is immunohistochemistry of paraffin-embedded Human tonsil tissue using CSB-PA038167(PAK4 Antibody) at dilution 1/20, on the right is treated with fusion protein. (Original magnification: ×200)
-
The image on the left is immunohistochemistry of paraffin-embedded Human ovarian cancer tissue using CSB-PA038167(PAK4 Antibody) at dilution 1/20, on the right is treated with fusion protein. (Original magnification: ×200)
-
Gel: 10%SDS-PAGE, Lysate: 40 μg, Lane: Human colon cancer tissue, Primary antibody: CSB-PA038167(PAK4 Antibody) at dilution 1/300, Secondary antibody: Goat anti rabbit IgG at 1/8000 dilution, Exposure time: 2 minutes
-
-
其他:
產品詳情
-
Uniprot No.:
-
基因名:
-
別名:KIAA1142 antibody; p21 activated kinase 4 antibody; p21 Cdc42/Rac1-actiated kinase 4 antibody; P21 protein (Cdc42/Rac) activated kinase 4 antibody; p21(CDKN1A) activated kinase 4 antibody; p21-activated kinase 4 antibody; PAK 4 antibody; PAK-4 antibody; Pak4 antibody; PAK4_HUMAN antibody; Protein kinase related to S.cerevisiae STE20 effector for Cdc42Hs antibody; Serine threonine kinase PAK 4 antibody; Serine/threonine protein kinase PAK 4 antibody; Serine/threonine protein kinase PAK4 antibody; Serine/threonine-protein kinase PAK 4 antibody
-
宿主:Rabbit
-
反應種屬:Human,Mouse
-
免疫原:Fusion protein of Human PAK4
-
免疫原種屬:Homo sapiens (Human)
-
標記方式:Non-conjugated
-
抗體亞型:IgG
-
純化方式:Antigen affinity purification
-
濃度:It differs from different batches. Please contact us to confirm it.
-
保存緩沖液:-20°C, pH7.4 PBS, 0.05% NaN3, 40% Glycerol
-
產品提供形式:Liquid
-
應用范圍:ELISA,WB,IHC
-
推薦稀釋比:
Application Recommended Dilution ELISA 1:1000-1:2000 WB 1:200-1:1000 IHC 1:25-1:100 -
Protocols:
-
儲存條件:Upon receipt, store at -20°C or -80°C. Avoid repeated freeze.
-
貨期:Basically, we can dispatch the products out in 1-3 working days after receiving your orders. Delivery time maybe differs from different purchasing way or location, please kindly consult your local distributors for specific delivery time.
-
用途:For Research Use Only. Not for use in diagnostic or therapeutic procedures.
相關產品
靶點詳情
-
功能:Serine/threonine protein kinase that plays a role in a variety of different signaling pathways including cytoskeleton regulation, cell migration, growth, proliferation or cell survival. Activation by various effectors including growth factor receptors or active CDC42 and RAC1 results in a conformational change and a subsequent autophosphorylation on several serine and/or threonine residues. Phosphorylates and inactivates the protein phosphatase SSH1, leading to increased inhibitory phosphorylation of the actin binding/depolymerizing factor cofilin. Decreased cofilin activity may lead to stabilization of actin filaments. Phosphorylates LIMK1, a kinase that also inhibits the activity of cofilin. Phosphorylates integrin beta5/ITGB5 and thus regulates cell motility. Phosphorylates ARHGEF2 and activates the downstream target RHOA that plays a role in the regulation of assembly of focal adhesions and actin stress fibers. Stimulates cell survival by phosphorylating the BCL2 antagonist of cell death BAD. Alternatively, inhibits apoptosis by preventing caspase-8 binding to death domain receptors in a kinase independent manner. Plays a role in cell-cycle progression by controlling levels of the cell-cycle regulatory protein CDKN1A and by phosphorylating RAN.
-
基因功能參考文獻:
- These results implicate a novel role for PAK4 within the PI3K pathway via interaction with p85alpha. Thus, PAK4 could be an essential player in PDAC progression representing an interesting therapeutic opportunity. PMID: 28205613
- This review will discuss the emerging data highlighting the prominence of PAK4 in Pancreatic distal adenocarcinoma(PDAC) and its potential role for transforming patient management. PMID: 29508632
- this series of compounds has the potential for further development as PAK4 inhibitors for anticancer activity PMID: 29443911
- X-ray crystallography reveals that in addition to the canonical PAK4 CDC42/RAC interactive binding (CRIB) domain binding to CDC42 there are unexpected contacts involving the PAK4 kinase C-lobe, CDC42, and the PAK4 polybasic region. PMID: 29295922
- High PAK4 expression is associated with glioma. PMID: 28677773
- These results indicate that miR485 acts as a tumour suppressor in Glioblastoma (GBM) by, at least partially, directly targeting PAK4 and regulating the AKT and ERK signalling pathways. Thus, miR485 may be a potential target for the treatment of patients with GBM. PMID: 29048626
- Study reports the overexpression of PAK4 in neuroblastoma cells and, that PF-3758309, a potent PAK4 inhibitor, inhibits cell proliferation and survival in neuroblastoma cells via inhibition of the MEK/ERK pathway. These results suggest a role of PAK4 in neuroblastoma development. PMID: 29048629
- Methylation at cg14010619 may modify PAK4 activity, which has been implicated in cisplatin resistance in malignant cell lines PMID: 28444219
- PAK4 downregulated the level of p21 and enhanced the activity of Akt as well. And we conclude that PAK4 acts as a regulator of cell cycle progression of vascular smooth muscle cells by mediating Akt signaling and controlling p21 levels, which further modulate intimal hyperplasia and vascular smooth muscle cells proliferation PMID: 28706947
- Findings revealed a novel function of PAK4 in thyroid stimulating hormone-induced papillary thyroid cancer progression. PMID: 28178642
- The present study demonstrates that miR-145 plays an important role in inhibiting cell migration by directly targeting PAK4, and identifies miR-145-PAK4-LIMK1-cofilin as a novel regulatory pathway that contributed to colorectal cancer metastasis. PMID: 28440035
- These findings revealed a novel glucose metabolism-related mechanism of PAK4 in promoting colon cancer cell growth, suggesting that PAK4 and/or G6PD blockage might be a potential therapeutic strategy for colon cancer. PMID: 28542136
- PAK4 (but not PAK1) mediates invadopodia maturation during melanoma invasion likely via inhibition of PDZ-RhoGEF. PMID: 27765920
- these results indicate that PAK4 confers CDDP resistance via the activation of MEK/ERK and PI3K/Akt pathways. PAK4 and PI3K/Akt pathways can reciprocally activate each other. PMID: 27919028
- PAK4 activity was markedly decreased in postmortem brain tissue from Parkinson's disease (PD) patients and in rodent models of PD. Expression of constitutively active PAK4(S445N/S474E) (caPAK4) protected DA neurons in both the 6-hydroxydopamine and alpha-synuclein rat models of PD and preserved motor function. PMID: 27903866
- Our results indicate that PAK4 plays an important role in the potentiation of insulin secretion by fatty acids downstream of GPR40. PMID: 27700527
- PAK4 downregulation decreased PPARgamma-mediated Nox1 expression and suppressed EMT in IR-treated glioma cells. PMID: 28534509
- miR-1271/Zic2/PAK4 axis plays an important role in hepatocellular carcinoma progression. PMID: 28577975
- findings suggest that PAK4-activated PI3K/AKT signaling is both kinase-dependent and -independent, which contributes to breast cancer progression PMID: 28407679
- Functional role and therapeutic targeting of PAK4 in multiple myeloma has been presented. PMID: 28096095
- PAK4 overexpression in hepatocellular carcinoma (HCC) promotes metastatic invasion by regulating p53 phosphorylation. PMID: 27496712
- Study demonstrated that PAK4 interacted with eEF1A1 to promote migration and invasion of gastric cancer cells, thereby providing new insights into the function of PAK4 and eEF1A1 in the progression of gastric cancer. PMID: 28393218
- The results support a novel connection between HIF-1a and Pak4 in hypoxic cancer cells, and provide insights into mechanisms whereby tumors respond to and thrive under oxygen-deficient conditions. PMID: 28288786
- Data suggest that signaling via ANP/ANPR (atrial natriuretic factor/ANP receptor) in vascular endothelial cells activates PAK4 (p21-activated kinase 4) and CCM2 (cerebral cavernous malformation 2 protein), resulting in phosphorylation of MLC (myosin light chain), cytoskeletal reorganization, and cell spreading; kinase homology domain of ANPRA (guanylyl cyclase-A) activates downstream targets of ANP/ANPR signaling. PMID: 28432261
- High expression of PAK4 is associated with breast cancer. PMID: 27297086
- In gastric cancer, High PAK4 expression was significantly correlated with clinicopathological variables related to tumour progression, including depth of invasion, metastatic lymph nodes, pathological stage, distant metastasis or recurrent disease. High PAK4 expression was significantly associated with poorer disease-specific survival and relapse-free survival. PMID: 26614788
- PAK4 methylation by SETD6 promotes the activation of the Wnt/beta-catenin pathway. PMID: 26841865
- Study has confirms prognostic role of PAK4 level in cervical cancer patients and recognizes the regulatory role in cervical cancer progression. PAK4 also confers the chemoresistance of cervical cancer cells in a PI3K/Akt-dependent way. PMID: 26411419
- PAK4 catalytic domain binds cellular ATP and the Inka1 inhibitor. The crystal lattice consists only of PAK4-PAK4 contacts, which form a hexagonal array with channels of 80 A in diameter that run the length of the crystal. PMID: 26607847
- PAK4 localizes to cell-cell junctions and contributes to estblishing cell polarity.PAK4 phosphorylate beta-catenin Serine-675.PAK4 binding to cell-cell junctions is dependent on Cdc42. PMID: 26068882
- Nuclear Pak4 is involved in the pathogenesis of endometrial cancer especially in postmenopausal women. PMID: 26218748
- data show decreased nuclear accumulation and transcriptional activity of STAT3 in PAK4-silenced pancreatic cancer cells PMID: 26546043
- this report reveals that high level of p-Pak4 correlates with poor prognosis in gastric cancer (GC), thereby suggesting that p-Pak4 might be a potential prognostic marker for GC. PMID: 26124003
- PAK4 and RhoU cooperate to drive adhesion turnover and promote cell migration. PMID: 26598620
- PAK4 mediated LIMK1 phosphorylation regulates the migration and invasion in NSCLC. Therefore, PAK4 might be a significant prognostic marker and potential therapeutic molecular target in NSCLC. PMID: 25975262
- CXCL12/CXCR4 signaling has a role in docetaxel-induced microtubule stabilization via p21-activated kinase 4-dependent activation of LIMK1 PMID: 25359780
- microRNA-433 (miRNA-433 directly targets PAK4 through the miRNA-433 binding sequence at the 3'-UTR of PAK4 mRNA. PMID: 25410752
- PAK1 and PAK4 expression were associated with colorectal cancer metastasis and infiltration PMID: 25791829
- PAK4 promotes alpha-MSH/UVB-induced melanogenesis via the CREB and Wnt/beta-catenin signaling pathways and suggest that PAK4 may be a potential therapeutic target in pigmentation disorders. PMID: 25560280
- Suggest that PAK4 is a regulator of NF-kappaB pathway in pancreatic cancer cells, controlling cell proliferation and survival. PMID: 25238288
- PAK4 phosphorylates Par6B at Ser143 blocking its interaction with Cdc42. PMID: 25662318
- Increased Pak4 expression can lead to development of adenomyosis by enhancing the invasiveness of endometrial cells through regulation of MMP-2 and -9 activities. PMID: 25637478
- PAK4 is known to act as a transporter for beta-catenin nuclear translocation. PMID: 24829151
- p21-activated kinase 4 inhibitor PF-3758309 shows anti-metastatic effect. PMID: 24366569
- PAK4-SCG10 signaling occurs in gastric cancer cell invasion. PMID: 23893240
- The results document an oncogenic role of PAK4 in repression of Smad2/3 transactivation that involved in tumorigenesis, and suggest PAK4 as a potential therapeutic target for gastric cancer. PMID: 23934187
- Both indole and indazole of KY-04031 are responsible for PAK4 hinge interaction. PMID: 24704155
- Mutation of this residue was sufficient to switch the phosphorylation site preference for multiple kinases, including the serine-specific kinase PAK4 and the threonine-specific kinase MST4. PMID: 24374310
- Genotype TT for rs9676717 in PAK4 gene and no drinking may be predictive of the interferon-a treatment success. PMID: 23652058
- we confirmed that the mechanisms of the Pak4-induced cell cycle arrest invovlve the activation of the ATM/Chk1/2/p53 pathway. PMID: 23229348
顯示更多
收起更多
-
亞細胞定位:Cytoplasm.
-
蛋白家族:Protein kinase superfamily, STE Ser/Thr protein kinase family, STE20 subfamily
-
組織特異性:Highest expression in prostate, testis and colon.
-
數據庫鏈接:
Most popular with customers
-
YWHAB Recombinant Monoclonal Antibody
Applications: ELISA, WB, IHC, IF, FC
Species Reactivity: Human, Mouse, Rat
-
Phospho-YAP1 (S127) Recombinant Monoclonal Antibody
Applications: ELISA, WB, IHC
Species Reactivity: Human
-
-
-
-
-
-